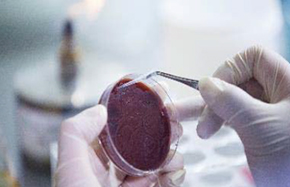

|
威斯腾生物立足于全国生命科学实验技术服务、生物医药研发检测及产品开发的高科技公司。是全国首家推出整体实验外包的专业服务机构,公司成立12年来,开展合作的单位超过300余家,为上10000名科研人员提供过生物科研实验技术服务。是国家级科技型企业、国家级高新技术企业、中关村海淀区生物医药公共研发检测平台、重庆市生物医药检测共享平台、重庆市生物医药研发重点实验室、2018年威斯腾生物荣获中国生命科学实验技术类唯一的“中国最受用户喜爱自主品牌奖”,在中国生物技术服务领域极具行业影响力!

威斯腾生物拥有完善的研究平台,包括七大服务平台:细胞生物学研究平台、分子生物学研究平台、病理学研究平台、免疫学研究平台、转基因及模型研究平台、蛋白质与多肽研究平台、测序和芯片研究平台。四大创新研发中心:CRISPR/Cas9靶向基因修饰药物开发平台、纳米靶向载药创新平台、高通量/高内涵筛选平台、分子表观遗传学研究平台。拥有4000平的实验场地及转化研究院,拥有各类科研设备总值超过6000万元,配有生物技术领域硕博以上各专业的技术工程师100余名。

威斯腾生物与澳大利亚昆士兰大学、新南威尔士大学、格里菲斯大学、上海中科院、上海复旦大学、北京中检院、北京大学药学院、陆军军医大学、重庆大学药学院、西南大学、重庆医科大学、重庆中药研究院、建立了紧密的产学研协同合作关系,与40余家国家重点实验室(教研室)签署合作协议,联合开展生物技术检测协同服务,可以盘活生物医药研发科研设备3亿多元,可以协调专业研发检测人员 700余名为全国的科研人员进行专业服务。







Construction and identification of animal models
威斯腾生物动物中心累积了丰富的动物培养、动物模型构建的经验,在模型动物构建上探索并累积了独特的实验方法,手术经验丰富,常规动物模型构建平均成功率98%以上;重难点模型 (开胸/开颅手术) 构建平均成功率75%以上,形成高校高质量的动物模型构建方法库,可成功构建上百种疾病动物模型。
荷瘤鼠模型
糖尿病模型
心肌梗死模型
大鼠MCAO模型
视网膜缺血模型
急性胰腺炎模型
脊髓损伤模型
脑立体定位注射致PD模型
裸鼠肿瘤模型(皮下)
脑立体定位(大鼠)

心脏离体灌流

颅脑损伤仪

心梗大鼠心脏TTC染色

MCAO模型大鼠脑部TTC染色

Cell Primary cell culture
威斯腾生物经过十余年的发展,掌握了上百种细胞株及四十余种原代细胞的培养经验,建立了庞大的细胞库及原代培养资料库;细胞平台拥有资深的实验员、 规范的SOP操作、 万级净化细胞房……这些条件为保质保量完成每个客户的实验提供了保障。
脑星形胶质细胞
皮层神经元细胞
小胶质细胞
血管内皮细胞
骨髓间充质干细胞
肿瘤干细胞(诱导)
血管平滑肌细胞
巨噬细胞
脾脏淋巴细胞
皮层神经元干细胞
骨髓源性内皮祖细胞
(EPCs)...
……

CRISPR/CAS9 project
威斯腾生物Cas9基因编辑团队组建于2011年,曾为全国各科研院所及中科院系统提供CRISPR/Cas9技术相关服务,完成60余例动物个体基因敲除。目前可提供单基因敲除/敲入细胞系构建、CRISPR/Cas9基因敲除动物等基因编辑相关服务,同时提供Cas9技术专业讲座,欢迎预约。

• 无物种限制
• 靶向精确性更高
• 对靶基因多个位点同时敲除
• 基因调控方式多种多样
• 修饰效率高,实验周期短

• 靶向基因沉默
• 体外DNA/RNA分子的
•位点特异性切割
• 基因定点突变
• 模式动物/细胞株改造


Fluorescence in situ hybridization
Research on the Interaction between Protein and DNA
Genomics solutions
MTT/CKK8检测
流式细胞术检测细胞周期
流式细胞术检测细胞凋亡
流式分选
细胞克隆形成实验
Transwell细胞迁移/侵袭实验
细胞划痕实验
细胞黏附性检测
RTCA(实时无标记细胞分析)
药物筛选
细胞膜片钳
石蜡包埋/切片
冰冻包埋/切片
免疫荧光
共聚焦显微镜拍照
Tunel检测
透射电镜
扫描电镜
Masson/油红“O”等特殊染色
基因合成/引物合成
基因测序
基因组DNA提取
RT-PCR检测
双荧光素酶检测
SNP检测(直接测序法)
甲基化测序检测(BSP法)
单基因敲除细胞系构建
LncRNA敲除细胞系构建
miRNA敲除细胞系构建
单基因激活细胞系构建
定点突变细胞系构建
基因敲除小鼠构建
基因敲入小鼠构建
转基因小鼠构建
WB检测
蛋白双向电泳
蛋白质免疫共沉淀(Co-IP)
单克隆抗体制备
多克隆抗体制备
多肽合成
蛋白质表达纯化
Elisa检测
表达谱芯片(Affymatrix/Angilent)
miRNA芯片(Affymatrix/Angilent)
Illumina人450K甲基化芯片
Affymatrix SNP芯片
LnRNA芯片
自噬诱导/抑制
自噬小体透射电镜观察
GFP-LC3单荧光指示体系
双荧光指标体系
自噬蛋白检测
大/小鼠骨髓微核试验
一般毒理试验
体外CHL细胞染色体畸变试验
精子畸形试验
发育毒性筛选试验
安全药理学筛选
16s/18s扩增子测序
ChIP-seq
单细胞测序
宏基因组测序
普通转录组测序
LnRNA测序
Small RNA测序
cirRNA测序
人全外显子测序
人全基因组测序
HuProtTM20K人类蛋白组芯片
细胞因子芯片
炎症因子芯片
仿制药开发
化学药物定制研发
生物等效性试验(BE试验)
药效学评价
蛋白组双向电泳
ITRAQ
SWATH
Lable-Free
LC-MS检测
GC-MS检测
NMR检测
腺病毒/慢病毒基因过表达
腺病毒/慢病毒基因干扰
腺病毒/慢病毒质粒构建
腺相关病毒设计构建
水迷宫试验
旷场试验
人工缺氧
小动物运动测试

博士、硕士、本科学历梯度的团队构成,多年从事生物和基础医学相关实验。
2000多名生物学、基础医学、临床医学、药学等相关领域专家顾问
基因测序、蛋白组学、代谢组学、芯片等服务与国内行业领先公司合作。
从实验安排到中间过程把关再到结果的综合汇总,均有专门部门进行质控审核,确保结果真实可靠。
分子生物学实验平台、细胞生物学实验平台、病理检测平台、动物建模平台。
完美的售前沟通、完善的报价体系、专业技术员操作及售后服务,让您没有后顾之忧;实验过程全程拍照,实验真实可靠。

可享受金牌代理商专属折扣
财年额外返点奖励

可享受银牌代理商专属折扣
财年额外返点奖励

可享受铜牌代理商专属折扣
财年额外返点奖励
公司为合作伙伴提供营销培训,包括专业知识、服务、产品知识等
公司长期在丁香通、生物通、生物在线等有影响力的行业网站投放广告宣传
不定期的进行各种节日促销活动、线下科研讲座等塑造威斯腾生物良好的品牌形象
提供全面的服务产品目录,各种产品手册、宣传折页、单页等宣传资料
享有公司全套技术支持,全程无忧服务,为客户提供及时的售前售后咨询服务解决代理商后顾之忧。
代理商按代理政策享受区域保护,协助代理商进行市场运作快速启动市场。